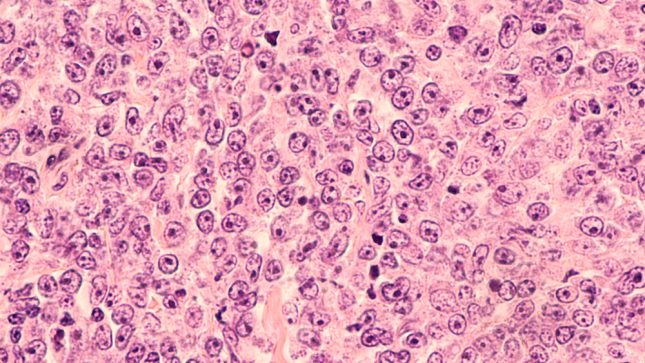
לימפומה-של-תאי-B. אילוסטרציה

לימפומה היא סוג של גידול ממאיר שמקורו בתאים של מערכת החיסון המכונים "לימפוציטים". לימפומה פוליקולרית שייכת לקבוצת לימפומות המכונה "לימפומה שאינה הודג'קין" ומהווה כחמישית מהלימפומות המאובחנות בישראל. המחלה פוגעת בדרך כלל באנשים מעל גיל 50, כשרוב המטופלים הם מעל גיל 60 והשכיחות שלה קצת יותר גבוהה בקרב גברים מאשר בקרב נשים.
אחד המאפיינים של המחלה היא שמהלך התקדמותה איטי, ומכאן נובע הביטוי "לימפומה זוחלת" המשמש לתיאור לימפומה זו. לדברי ד"ר נג'יב דלי, מנהל המכון ההמטולוגי ובנק הדם במרכז הרפואי זיו, "לימפומה פוליקולרית היא מחלה לא אלימה המתקדמת לרוב באיטיות. לכן, חלק מהמטופלים לא יזדקק לטיפול לעולם ובמקרים מסויימים תתכן אפילו נסיגה ספונטנית וריפוי של המחלה".
כיצד מאבחנים את המחלה?
לדברי ד"ר דלי, "ברוב המקרים המחלה מאובחנת לראשונה כאשר ישנה הגדלה לא כואבת של קשריות לימפה במקומות שונים בגוף, כמו בצוואר, בבתי השחי ובמפשעות, ללא סיבה ברורה". לדבריו, "לעיתים בדיקות הדמיה של החזה והבטן מגלות קשריות לימפה מוגדלות וכך מתגלה המחלה".
כ-85 אחוזים מהמקרים מאובחנים בשלבים המתקדמים של המחלה, שכן לרוב היא אינה גורמת לתסמינים. תסמינים שכיחים ללימפומה מתקדמת כוללים בין השאר ירידה במשקל, חום (ברמה נמוכה, סביב 38 מעלות ולרוב לקראת הערב) והזעות לילה.
כאמור, כיוון שהמחלה מתקדמת באיטיות היא לרוב מתגלה בשלב מתקדם, וקשה לרפא אותה לחלוטין. הסיבה לכך שהמחלה מתקדמת לאט טמונה בעובדה שהתאים הסרטניים במחלת הלימפומה הפוליקולרית מתחלקים בקצב איטי יותר. למרות שהטיפול יעיל באופן כללי, לעיתים קרובות עשויה להימצא שארית של תאים, ומכאן נובעת הנטייה של המחלה להשנויות.
מה הטיפול במחלה?
מטופלים ללא תסמינים לא מקבלים טיפול למחלה כלל, גישה המכונה "watch and wait" ("צפה והמתן"). כלומר, המטופלים שאינם זקוקים לטיפול עוברים מעקב המטולוגי קפדני אחר התקדמות המחלה, ורק במידה והיא מתקדמת, הם מקבלים טיפול. "ברוב המקרים, לימפומה פוליקולרית נוטה להתנהג כמו מחלה כרונית שבה האנשים חווים תקופות ארוכות של בריאות טובה יחסית, לצד התקדמות של המחלה לפרקי זמן מסוימים. בפרקי זמן אלו, המטופל מקבל טיפול ולרוב נכנס להפוגה ארוכה יחסית של מספר שנים. עם התקדמות המחלה, ההפוגות מתקצרות והמחלה הופכת ליותר פעילה, ולעיתים המחלה מתקדמת ללימפומה אגרסיבית" אמר ד"ר דלי.
לדברי ד"ר דלי "הטיפול בלימפומה פוליקולרית משתנה כתלות במצב המטופל. כאשר המחלה ממוקמת ומערבת אזור בודד של קשריות לימפה, ייתכן וטיפול קרינתי לאזור זה יגרום לריפוי של המחלה. עם הופעת התסמינים (התקדמות המחלה) ברוב המקרים הטיפול כולל שילוב של טיפול כימותרפי וטיפול ביולוגי יחד. הטיפול אותו מתאר ד"ר דלי כולל בדרך כלל טיפול בכימותרפיה ובנוגדן כנגד חלבון מסוים הנמצא על גבי התאים הסרטניים. הבחירה בסוג הכימותרפיה תלויה במאפייני המטופל ומשתנה בהתאם לגילו, למחלות הרקע שלו ולגורמים נוספים.
מטופל עם לימפומה פוליקולרית צפוי ליהנות ממספר שנים של הפוגה במהלכה לא יזדקק לטיפולים נוספים וייהנה מאיכות חיים טובה. יחד עם זאת, ישנה קבוצה של מטופלים שמחלתם לא תגיב לטיפול או תישנה כעבור זמן קצר, ולהם צפוי מהלך יותר מורכב ופרוגנוזה פחות טובה. "אחד הסימנים הלא טובים הוא הישנות המחלה בפחות מ-24 חודשים לאחר מתן טיפול" מציין ד"ר דלי. הטיפול בחולים אלו עלול להיות מאתגר ויכול לכלול מספר טיפולים אפשריים, ביניהם משלבי כימותרפיה שונים, הקרנות וטיפולים ביולוגים. הקושי בטיפול בקבוצת חולים זו עודד את הקהילה הרפואית לחקור את הנושא ובשנים האחרונות חלו התפתחויות רבות ומשמעותיות בתחום.
מה הן ההתפתחויות החדשות בתחום?
בשנים האחרונות נבדקות מספר תרופות ביולוגיות וטכנולוגיות לטיפול בלימפומה פוליקולרית שמציגות יעילות גבוהה ותופעות לוואי מתונות יחסית. מפיתוחים אלו עשויות להתווסף בעתיד מספר אפשרויות טיפול המתבססות על רתימת מערכת החיסון עצמה לטיפול בלימפומה. ביניהן ניתן למנות שיטות של הנדסה גנטית ונוגדנים מדור חדש המעודדים את הרס תאי הלימפומה ע"י תאי מערכת החיסון. ד"ר דלי מציין כי כיום ישנם שני פיתוחים עיקריים שעשויים לשנות את הטיפול במחלה. לדבריו, הפיתוח הראשון הוא "נוגדנים מיוחדים שיכולים להיקשר במקביל לתאי הגידול ולתאי מערכת החיסון מסוג T ולקרב ביניהם, ובכך לרתום את המערכת החיסונית של המטופל עצמו להשמדת תאי הגידול. נוגדנים מסוג זה מאושרים לטיפול בממאירויות המטולוגיות אחרות".
אפשרות טיפול עתידית נוספת אשר משמשת כיום לטיפול בממאירויות המטולוגיות נוספות, מציין ד"ר דלי, היא טיפול בתאים מיוחדים המכונים תאי CAR-T – "מדובר בתאי המערכת החיסונית המכונים "לימפוציטים מסוג T", אשר עליהם מבצעים הנדסה גנטית במעבדה על מנת שיזהו את תאי הגידול של אותו מטופל כזרים ויתקפו אותם. לטיפול מספר שלבים הכולל איסוף תאים מהמטופל, הכנתם במעבדה ובהמשך החזרתם למטופל. מדובר בשיטה שיכולה לגרום להפוגות ארוכות, אך ימים יגידו אם הצלחנו לרפא חלק מהמטופלים ע"י שימוש בטכניקה זו".
בשנים הקרובות, טכנולוגיות ותרופות חדשות עשויות להיכנס לטיפול השגרה בלימפומה פוליקולרית, מה שעשוי לתת תקווה רבה לחולים שמחלתם נשנתה או לא הגיבה לטיפולים הסטנדרטים. ד"ר דלי מסכם בכך ש"בעבר הטיפול היחיד הזמין למחלה עמידה היה השתלת מח עצם עצמית (איסוף תאי אב מהמטופל עצמו) שבאמצעותו הארכנו את השרידות של מטופלים אלה. בשנים האחרונות, אנו עדים להתפתחויות פורצות דרך הכוללות ניווט והפעלה של המערכת החיסונית של המטופל עצמו כנגד התאים הסרטניים". הוא הוסיף כי "שיטות אלה נחשבות היום כחוד החנית של הטיפול במחלות המטואונקולוגיות שונות".
יש להדגיש כי בחירת הטיפול האפשרי הינה להחלטת המטפל הרושם את המרשם בהתייעצות עם המטופל. המידע נכון לספטמבר 2022. למידע נוסף ,יש לפנות לרופא המטפל.
שירות לציבור. מוגש בחסות חברת רוש פרמצבטיקה (ישראל) בע"מ.